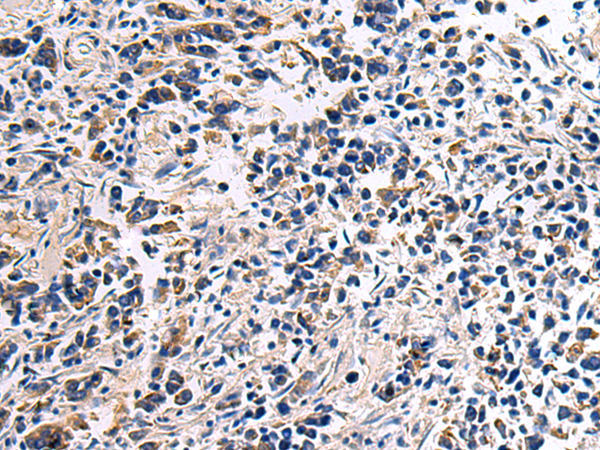
一抗

|
Background: |
Transcription factor required for the formation of correct projections from nociceptive sensory neurons to the dorsal horn of the spinal cord and normal perception of pain. |
|
Applications: |
ELISA, IHC |
|
Name of antibody: |
DRGX |
|
Immunogen: |
Synthetic peptide of human DRGX |
|
Full name: |
dorsal root ganglia homeobox |
|
Synonyms: |
DRG11; PRRXL1 |
|
SwissProt: |
A6NNA5 |
|
ELISA Recommended dilution: |
5000-10000 |
|
IHC positive control: |
Human breast cancer |
|
IHC Recommend dilution: |
50-200 |

 購(gòu)物車
購(gòu)物車 幫助
幫助
 021-54845833/15800441009
021-54845833/15800441009